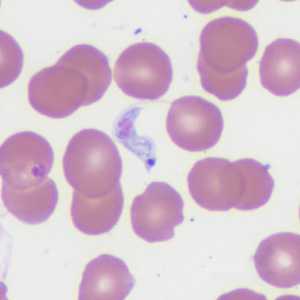
Case372_B
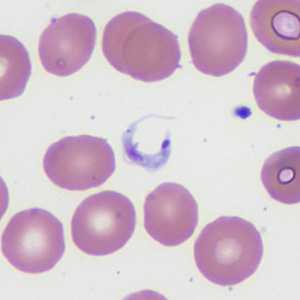
Case372_D

Case #372 - May 2014
A 45-year-old patient originally from Mexico presented with a left groin lymphocele, erythema, swelling in his lower extremities, and fever and chills approximately one month after receiving a heart transplant. An endomycardial biopsy was performed and blood specimens were collected in EDTA and sent to Hematology for work-up. Objects of interest were observed by the attending pathologist on a thin blood film stained with Wright stain. Images were captured and sent to the DPDx Team for diagnostic assistance. Figures A-D show four of the images submitted. What is your diagnosis? Based on what criteria?

Figure A
Figure B

Figure C
Figure D
Case Answer
This was a case of Chagas disease (American trypanosomiasis) caused by Trypanosoma cruzi. Diagnostic morphologic features included:
- trypomastigote forms of the parasite with a large posterior kinetoplast and an undulating membrane with an anteriorly-directed flagellum (Figures A-D).
- trypomastigotes exhibiting a C-shaped form (Figures A and D).
The patient’s origin in Latin America was also important, as the other human trypanosome species, T. brucei, is endemic to Africa.
More on: American Trypanosomiasis
This case and images were kindly provided by Aurora St. Luke’s Medical Center, Milwaukee, WI.
Images presented in the monthly case studies are from specimens submitted for diagnosis or archiving. On rare occasions, clinical histories given may be partly fictitious.
DPDx is an education resource designed for health professionals and laboratory scientists. For an overview including prevention and control visit www.cdc.gov/parasites/.
- Page last reviewed: August 24, 2016
- Page last updated: August 24, 2016
- Content source:
- Global Health – Division of Parasitic Diseases and Malaria
- Notice: Linking to a non-federal site does not constitute an endorsement by HHS, CDC or any of its employees of the sponsors or the information and products presented on the site.
- Maintained By:


 ShareCompartir
ShareCompartir